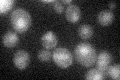
YIR002C
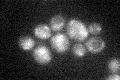
YIR002C

View description
Member of the DEAH family of helicases, functions in an error-free DNA damage bypass pathway that involves homologous recombination, binds to flap DNA and stimulates activity of Rad27p and Dna2p; mutations confer a mutator phenotype
Localization:
Intensity:
Fold change:
Significance:
-
C’ GFP library in SD
nucleus20 -
N' NOP1pr-GFP in SD

punctate,nucleus50.9165 -
N' TEF2pr-mCherry in SD

nucleus39.8605 -
N' NATIVEpr-GFP in SD

below threshold19.1056 -
N' TEF2pr-VC and Cyto-VN in SD

nucleus30.8996 -
C’ GFP library in SD+DTT

nucleus21.551.07No -
C’ GFP library in SD+H2O2
nucleus21.161.05No -
C’ GFP library in Starvation Media

nucleus18.830.94No -
C’ GFP library on the background of Pup2-DaMP

nucleus -
C’ GFP library on the background of CCT mutant

nucleus22.54091.12654No
